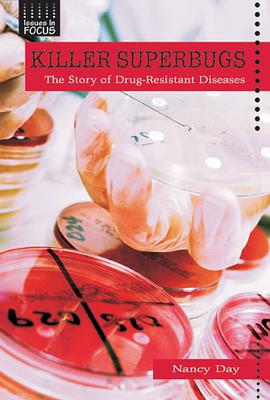

具体描述
-- These over-100-page titles present the facts and analyze some of the most controversial topics in today's news.-- Offers excellent and up-to-date information for reports or debates.-- Helps teenagers to begin developing critical thinking skills.
作者简介
目录信息
读后感
评分
评分
评分
评分
评分
用户评价
评分
评分
评分
评分
评分
相关图书
本站所有内容均为互联网搜索引擎提供的公开搜索信息,本站不存储任何数据与内容,任何内容与数据均与本站无关,如有需要请联系相关搜索引擎包括但不限于百度,google,bing,sogou 等
© 2026 book.quotespace.org All Rights Reserved. 小美书屋 版权所有




















